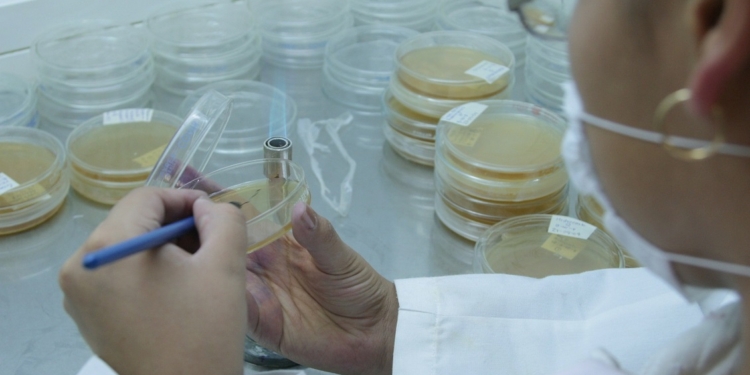

CIUDAD DE MÉXICO, 23 de agosto (AlmomentoMX).- La aplicación Biotecnológica en México quedó rebasada por otros países como Taiwán y Corea del Sur, debido a una visión equivocada de quienes definen las políticas de Estado, al optar por “convertirnos en un país maquilador, en lugar de visualizarnos como un país desarrollador de tecnología”, aseveró el doctor Gustavo Viniegra González, investigador del Departamento de Biotecnología de la Universidad Autónoma Metropolitana (UAM).
El investigador nacional emérito, dedicado desde hace décadas a la fermentación sólida un campo muy restringido de la biotecnología, dijo que espera “que el nuevo gobierno entienda que sin innovación no se podrá lograr nada de lo que piensan hacer en materia de ciencia y tecnología”.
En entrevista con motivo del Primer Seminario Internacional de Biotecnología y la 12a Semana de la Biotecnología, que se realizará del 10 al 14 de septiembre en la Unidad Iztapalapa de la UAM, dijo que el desarrollo de esa disciplina en México se remonta a 1950, cuando el doctor Alfredo Sánchez Marroquín empezó a realizar fermentaciones industriales para producir penicilina y fue pionero en estudiar las fermentaciones del nopal y del maguey, concretamente el pulque y el tequila.
También destacaron otros investigadores como los doctores Carlos Casas Campillo, uno de los primeros en elaborar proteína unicelular de los hidrocarburos; Francisco Bolívar Zapata, uno de los precursores de la ingeniería genética mundial, y Luis Herrera Estrella, quien hizo un trabajo de vanguardia en la Universidad de Gante para desarrollar la ingeniería genética de plantas.
Todos ellos regresaron a México y continuaron haciendo grandes contribuciones para que algo que era muy incipiente y académico se convirtiera en un campo de gran utilidad práctica para la industria, dijo el Profesor Emérito de la UAM.
Algunos investigadores como la doctora Mayra de la Torre, premio nacional de ciencias y especialista en construir reactores que ayudan a las empresas, por ejemplo a producir pesticidas, o los doctores Oscar Monroy Hermosillo o Sergio Revah Moiseev, Profesores Distinguidos de la UAM, que desarrollaron trabajos que nos sirven para entender el avance de las plantas de tratamiento de agua y que aportan su conocimientos a la ingeniería sanitaria por medio de la biotecnología.
Con estos antecedentes, el doctor Viniegra González consideró que México empezó a participar a tiempo –desde los años 50 del siglo pasado– en el avance de la disciplina, sin embargo “a pesar de que siempre estuvimos actualizados, hemos tenido que sufrir una plaga tremenda que se llama los secretarios de Hacienda, que desde hace 30 años han considerado más necesario tener un país de maquiladores que de desarrolladores de tecnología”.
México estaba al mismo nivel de Corea del Sur o Taiwán, y ahora ya “nos rebasaron, con lo que la aplicación industrial ha quedado en desventaja debido a esa visión equivocada de convertirnos en maquiladores, en lugar de adaptar, asimilar, reinventar e inventar tecnología”, sin embargo, pese a este rezago “podemos recuperarnos”, señaló el académico.
El reto para México es sustituir al petróleo en no más de 20 años y tal objetivo sólo se alcanzará con innovación, creatividad y organización, así como explorando nuevos campos para el desarrollo de la biotecnología mexicana.
La intención es producir biocombustible y productos derivados de la bioquímica, pero nadie se pregunta de dónde saldrá la materia prima, pues se requieren cantidades enormes, además de que casi todos los experimentos realizados en los centros de investigación han sido copias de lo que se ha hecho en Brasil, Estados Unidos o en algunos países de Europa, donde quieren producir con el maíz “que aquí necesitamos para comer” o con la caña de azúcar.
El investigador mencionó que en México “no podemos hacer eso porque carecemos de cultivos de esa magnitud y porque 45 por ciento de la superficie nacional es árida o semiárida”, sin embargo esta condición “nos da ventaja mundial”.
Esas áreas son resultado de un campo evolutivo de cientos de millones de años, que permitió que se generaran plantas como el maguey y el nopal, que crecen muy bien en este terreno y producen tanto como la caña de azúcar o el maíz, pero con cinco veces menos agua”.
Hasta ahora se sabe que del maguey se produce tequila y los nopales son consumidos como alimento, pero “no nos hemos dado cuenta de que podemos generar cantidades enormes de gas etanol a partir del nopal así como fibra y bioplásticos a partir del maguey, con muy poca agua.
“Tampoco hemos considerado que la gente que vive en estas zonas es muy pobre y que podría dejar de serlo si se le ofreciera la oportunidad de aprovechar sus tierras con ese fin”, advirtió.
El doctor Viniegra González dijo que frente a estos retos, el nuevo biotecnólogo debe ser alguien que no sólo sepa de microbios, enzimas o reactores, sino que también entienda a los seres humanos, que comprenda que existen intereses sociales y políticos, y se enfoque en la resolución de los problemas de pobreza y de miseria.
El reto de la disciplina es formar un tipo de profesional integrado a la realidad ecológica, social, económica y política, y en ese sentido “ojalá el nuevo gobierno entienda que sin innovación no se va a poder lograr nada de lo que piensan hacer”, en todo caso el cambio tendrá que venir desde abajo.
Respecto de la 12a Semana de Biotecnología dijo que ésta es organizada por alumnos del Departamento de Biotecnología “porque consideramos que deben tener tareas extracurriculares que les permitan desarrollar sus capacidades de organización y liderazgo”, y en ese sentido representa una gran oportunidad de encuentro con la realidad de ese campo del país.
El docente consideró que la Semana ha tenido un gran crecimiento que se refleja en el interés de los alumnos y profesores de otras instituciones educativas públicas y privadas, así como también de empresas nacionales e internaciones que tienen todo el entusiasmo de participar, aunado al aporte de Emmanuel Iván Díaz de León Clara, alumno de la Licenciatura en Ingeniería Bioquímica Industrial y organizador del foro.
Díaz de León Clara ha coordinado la actividad desde hace tres años y en esta ocasión decidió crear el Primer Seminario Internacional de Biotecnología que se fusiona con la 12a Semana de Biotecnología, lo cual “es el reflejo de la buena orientación que permitió desarrollar sus habilidades” y su capacidad de incrementar la cantidad de empresas que participan año con año, entre otras Sartorios de México, Yakult, Merck, Fuller, Sigma Alimentos, Sociedad Cooperativa Pascual, DKT México, Mobike México y GRESMEX.
Los principales impactos de este encuentro radican en el creciente interés por participar, por ejemplo, en los ciclos de conferencias con académicos y egresados distinguidos como la doctora Patricia Villalobos Oliver, directora de Investigación y Desarrollo Corporativo del Grupo Bimbo y egresada de la Licenciatura en Ingeniería Bioquímica Industrial y del Posgrado en Biotecnología; el ingeniero Javier Peralta Flores, director Corporativo de Calidad en Nature Sweet Inc. USA y egresado de la Licenciatura Ingeniería Bioquímica Industrial.
También acudirán representantes del sector industrial como la maestra Yolanda Villegas González, Head of Legal, Regulatory and Compliance of Vitol México; el ingeniero Gaspar Franco Hernández, integrante de la Comisión Nacional de Hidrocarburos, y la doctora María Amparo Martínez Arroyo, directora general del Instituto Nacional de Ecología y Cambio Climático; además se llevarán a cabo mesas sobre el tema educativo y el mercado de trabajo en el ramo.
Una de las actividades de esta Semana es la entrega del Reconocimiento Alumno-Profesor que en esta ocasión se entregará al doctor Ernesto Favela Torres, Profesor Distinguido de la Casa abierta al tiempo, por su gran labor en la formación y motivación de varias generaciones de biotecnólogos.
AM.MX/fm
The post Desacierto de México ser maquilador, en vez de desarrollador de tecnología appeared first on Almomento.Mx.
Powered by WPeMatico